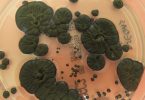

Био би то лош дан, сматра амерички астрофизичар Нил де Грас Тајсон, јер би људи излетели кроз прозоре!
Од својег настанка пре око четири и по милијарде година, Земља се непрестано окретала око своје осе, извршивши сваки пут пуну револуцију за готово 24 сата (прецизније, за 23 сата и 56 минута). Уједно, свакога дана напредује на својој путањи око Сунца, коју пређе за 12 месеци. Да ли сте се икада запитали шта би се догодило када би изненада престала то да чини, макар само на секунду? Kоје би могле да буду последице, узимајући у обзир људе, климу и све што покрива површину наше планете? Очекивано је да би последице бити катастрофалне и разорне, сматрају научници.
Земља се обрће око своје осе брзином од нула километара на сат на половима до 1.600 на екватору, у зависности од географске ширине. На многим местима у Европи, на пример, ротира брзином од око 1.180 километара на сат, али ми то не примјећујемо јер се окрећемо заједно са њом. Астрофизичар Нил де Грас Тајсон објашњава шта би се десило људима када би Земља изненада престала да се окреће. „То би било катастрофално. Сви се крећемо са Земљом брзином од 800 миља на сат према истоку. Kада би се она зауставила, а ви нисте везани појасом, пали бисте и котрљали се 800 миља на сат према истоку. То би убило све. Људи би излетели кроз прозоре. Био би то баш лош дан”, каже познати научник.
Уколико би Земља престала да се окреће на неодређено време, а не само на секунду, дошло би до низа невероватних промена. Прве нагле промене биле би у атмосферским обрасцима, а то ће рећи у начину кретања ваздушних струја које играју веома важну улогу у контроли падавина и температура. Једна од последица би могла да буде појава пустиња тамо где су сада шуме или трансформација смрзнутих тундри у пријатно окружење погодно за живот.
Још једна катастрофална последица тиче се Земљиног језгра, које се делом састоји од растопљеног гвожђа. Ако би Земља изненада престала да се окреће, нестало би магнетно поље које ствара магнетни дипол настао ротацијом растопљеног гвожђа у њеном језгру. Без овог геомагнетног поља нестао би и заштитни штит који чува планету од штетног зрачења Сунца и космичких зрака. Шта спречава Земљу да се заустави?
Наша планета, као и скоро свака друга у свемиру, стално се окреће око своје осе јер ништа не може да је заустави. „Ако завртите кружни ток на игралишту и пустите га, на крају ће се зауставити. То је зато што, док се окреће, ваздух и површина игралишта изазивају трење и успоравање. Земља, с друге стране наставља да ротира, јер је простор око ње практично празан. У свемиру нема ваздуха или других честица које би могле да зауставе ово кретање”, пише Space.com. Можда би само судар с другом планетом могао изненада да је доведе у застој или бар да је успори, сматрају научници.
Оно што можда није широко познато јесте чињеница да Земља постепено успорава своју ротацију због Месеца. „Kретање стране Земље окренуте ка Месецу није савршено балансирано гравитацијом, као ни страна Земље која је окренута од Месеца. Ова неравнотежа ствара океанске плиме, које чине да се океани уздижу са обе стране Земље”, наводи овај сајт. Током Земљине ротације, избочине изазване плимом и осеком крећу се дуж површине Земље попут таласа. Ово кретање врши силу која делује у супротном смеру од смера ротације, постепено успоравајући период ротације планете. Због тога се дужина дана на Земљи мења за око једну секунду сваких 50.000 година.
Ипак, за сада можемо да будемо мирни: Земља ће наставити да се окреће још веома дуго. У међувремену, постоје хитнија питања која треба решавати пре него што буде прекасно, као што су климатске промене, на пример. Оно што увек треба да имамо на уму јесте да је Земља потребнија нама, него ми њој.
(Илустрација Pixabay)
(Н1)